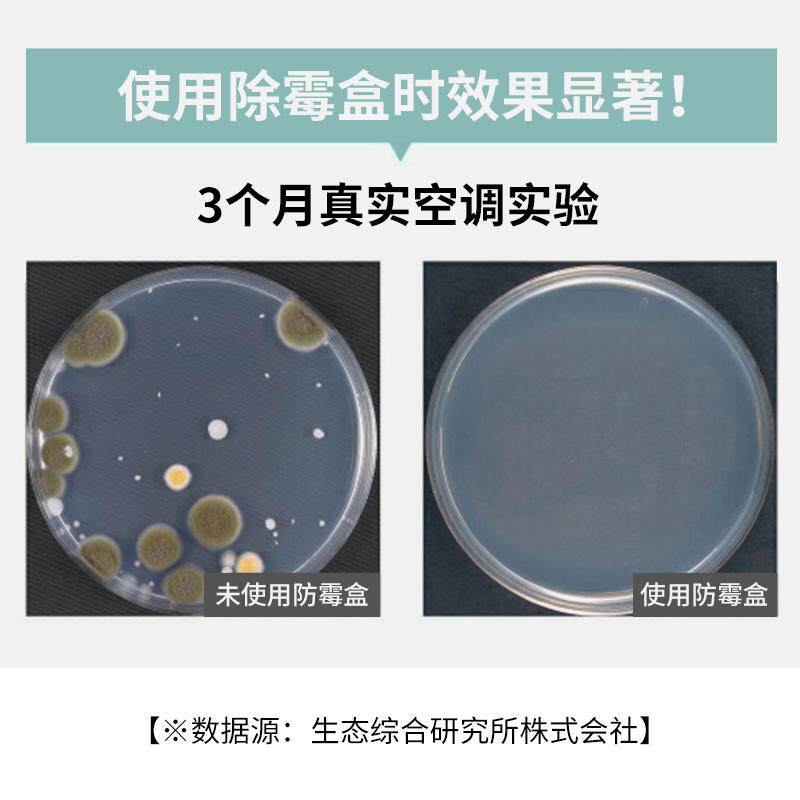

市 场 价:68 元
折 扣 价:68 元
所 在 地:上海
店铺掌柜:爱嘉生活
去购买>> 下架了的话点我重新搜索本站来源:淘宝(www.xiuda.net)购物与天猫(www.tianmaocn.com)是一个知名的电商平台,淘宝同时您也可以访问(www.taobwg.com)来发现更多精彩的购物选择。 樟脑丸衣柜防霉防虫防潮除味驱虫除湿卫生球防蟑螂丸花香防蛀防霉 防霉樟脑丸家用防虫防蛀衣柜除味驱虫卫生樟脑球衣橱用防潮蟑螂丸 雪松木樟脑丸进口香樟木衣柜防霉防虫衣物防潮卫生球家用防蛀去味 樟脑丸防虫防霉衣柜去味除臭驱虫防蛀网袋除霉剂卫生球清香防虫饼 进口ORPHEA奥菲雅天然衣柜防虫防蛀防霉除味香片包替代樟脑丸15片 雪松木樟脑丸进口香樟木衣柜防霉防虫衣物防潮挂木条家用防蛀去味 orphea奥菲雅羊绒衣物防蛀防霉香片15片驱虫除味天然樟脑丸 芳香樟脑丸独立包装 衣柜防霉防蛀片去霉味防虫驱除蟑螂卫生球防潮 利威香樟木粉衣柜防霉防蛀天然防虫家用衣物收纳小包代樟脑丸球 雪松木樟脑丸进口香樟木衣柜防霉防虫衣物防潮卫生球家用防蛀去味 日本进口金鸟防霉防蛀片樟脑丸驱虫除衣服异味霉味衣柜驱蟑螂24片 雪松天然樟脑丸块羊毛衣物柜书籍档案防虫防蛀宿舍防霉防潮卫生球 花香樟脑丸衣柜防霉防虫防潮防蛀蟑螂家用无毒衣服驱除异味日本球 ORPHEA奥菲雅樟脑丸羊绒衣物衣柜防霉防蛀驱虫除味60片组合香型 雪松木樟脑丸进口香樟木衣柜防霉防虫衣物防潮卫生球家用防蛀去味